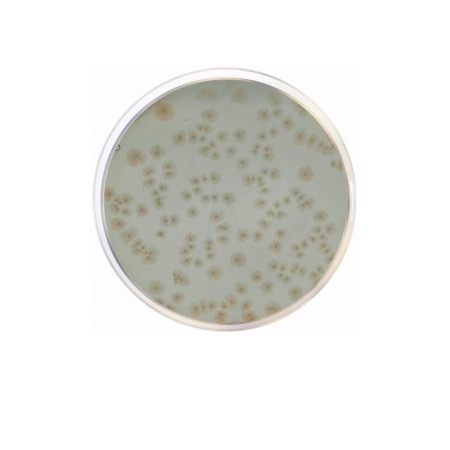
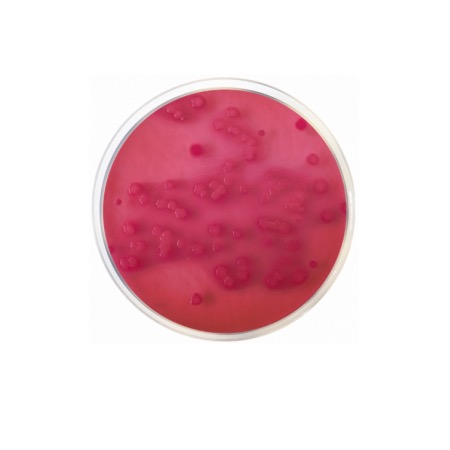
product
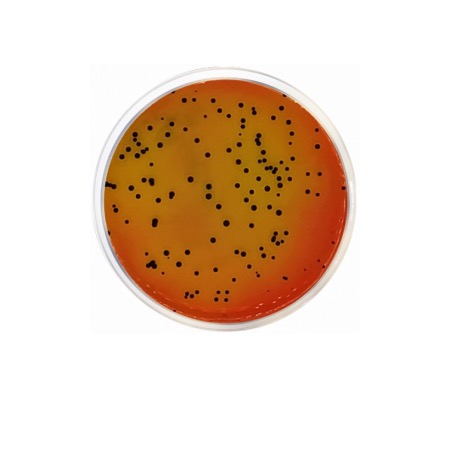
product

Wilkins Chalgren Medium is engineered to provide all the essential nutrients required by fastidious anaerobes. The Peptone Mixture and Tryptic Casein Digest provide a rich source of nitrogen, amino acids, and peptides. Yeast Extract supplies essential B-complex vitamins and growth factors. Glucose serves as the primary energy source. The medium is specifically supplemented with Hemin (providing X-factor) and Vitamin K1, both of which are critical for the growth of many Bacteroides species and other gram-negative anaerobes. L-Arginine is included to stimulate the growth of Eubacterium lentum and other species. Sodium Chloride maintains osmotic balance, while Pyruvate acts as an energy source and helps neutralize toxic peroxides that may form in the medium.
Advantages
- Standardized for Susceptibility Testing: Recommended by international committees (such as CLSI) for determining the Minimum Inhibitory Concentration (MIC) of antibiotics against anaerobes.
- Blood-Free Growth: Successfully supports the growth of most clinically significant anaerobes without requiring blood supplementation, though blood can be added if desired.
- Rich Nutrient Profile: Specifically supplemented with Hemin, Vitamin K, and Arginine to ensure the recovery of fastidious species.
- Enhanced Cell Viability: The inclusion of Sodium Pyruvate helps protect anaerobic cells from oxidative stress.
- Consistent Performance: Formulated to provide excellent reproducibility in antibiotic disc diffusion and agar dilution assays.
Technical specifications
| Catalogue number |
1503 |
| Brand |
Condalab |
| Application |
Cultivation and antimicrobial susceptibility testing of anaerobes |
| Typical Composition (g/L) |
Tryptic Casein Digest (10.0); Peptone Mixture (10.0); Yeast Extract (5.0); Glucose (1.0); Sodium Chloride (5.0); L-Arginine (1.0); Sodium Pyruvate (1.0); Hemin (0.005); Vitamin K1 (0.0005); Bacteriological Agar (15.0) |
| Final pH (at 25 °C) |
7.1 ± 0.2 |
| Preparation |
48.0 g/L |
| Storage Temperature |
2 – 25 °C |
Available packaging options
| 1503 |
500 g plastic bottle |